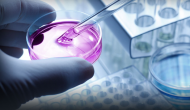

本周三FDA公開了內(nèi)部專家對百健/衛(wèi)材粉狀蛋白抗體aducanumab的上市申請給出非常積極的評價,說臨床數(shù)據(jù)非常有說服力、并否認腦水腫副作用起到揭盲作用。但其中一個統(tǒng)計學(xué)家提出不同意見,
Continue reading …
今天施貴寶宣布其口服小分子藥物、TYK2抑制劑Deucravacitinib (BMS-986165) 在一個叫做Poetyk-PSO-1 的三期臨床同時擊敗安慰劑和另一個口服小分子藥物
Continue reading …
這兩天改裝CAR-T企業(yè)Unum和Bellicum先后發(fā)布不利消息。先是昨天BLCM宣布裁員79%,將集中精力開發(fā)靶向PSCA的BPX-601和靶向HER2的BPX-603。BPX-601僅在實體瘤產(chǎn)生一些穩(wěn)定疾病而沒有任何應(yīng)答,而BPX-603剛剛開始臨床、還要面臨各種HER2新療法的擠壓。今天Unum則宣布更名為Cogent,并招了一位新CEO。今年3月Unum也曾裁員60%,放棄已經(jīng)進入臨床的ACTR707和087、把重點放到臨床前。現(xiàn)在這兩個CAR-T先驅(qū)都成為市值不到1億美元的小微企業(yè)。
Continue reading …
最近Shasqi公司發(fā)明了一個點擊化學(xué)新用法,用于向腫瘤組織遞送化療藥物。 這個叫做Click Activated Protodrugs Against Cancer (CAPAC)的技術(shù)平臺有兩個組成部分,
Continue reading …
這一期的《新藥發(fā)現(xiàn)》雜質(zhì)發(fā)表一篇阿斯列康科學(xué)家的分析,作者想看看新生物功能是不是一定需要新化學(xué)反應(yīng)實現(xiàn)。
Continue reading …
今天FDA正式批準了吉利德科學(xué)的抗病毒藥物瑞德西韋(商品名Veklury)用于12歲以上、體重40公斤以上需要住院治療的新冠患者,同時也獲得了體重3.5公斤以上12歲以下兒童患者的緊急使用資格(EUA)。FDA要求吉利德在這個產(chǎn)品正式批準后提供三個關(guān)鍵三期臨床ACTT-1, GS540-5773, 和GS-US-5774的病毒載量和傳播數(shù)據(jù)。這是美國第一個正式批準的新冠藥物,專家估計今年銷售可達28億美元、如果新冠明年繼續(xù)流行這個產(chǎn)品銷售可達50億美元。受此消息影響今天吉利德收盤后上揚4%。
Continue reading …
最近組織結(jié)構(gòu)場理論(tissue organization field theory, TOFT)的倡導(dǎo)者Soto教授再度發(fā)聲、在《Plos生物》發(fā)表一篇題為Over a century of cancer research: Inconvenient truths and promising leads的文章聲討主流的體細胞變異(SMT)腫瘤學(xué)說,說過去近百年腫瘤治療進展緩慢是因為概念框架就錯了。TOFT理論認為細胞內(nèi)發(fā)生的事情如細胞核、細胞膜、線粒體、ER、代謝等變化與腫瘤沒多大關(guān)系,基因變異與腫瘤發(fā)生無關(guān)、只是個伴隨現(xiàn)象。
Continue reading …
今天諾貝爾基金會宣布2020年諾貝爾化學(xué)獎授予普朗克研究所的法國生物化學(xué)家Emmanuelle Charpentier教授和加州大學(xué)伯克利分校生物化學(xué)家Jennifer Doudna教授
Continue reading …
今天諾貝爾基金會宣布2020年諾貝爾生理學(xué)或醫(yī)學(xué)獎授予NIH的Harvey Alter博士、阿爾伯塔大學(xué)的Michael Houghton博士、和洛克菲勒大學(xué)的Charles Rice博士,
Continue reading …
今天默沙東宣布過去7年掌舵其百億研發(fā)活動的總監(jiān)Roger Perlmutter博士即將離任,接替這個位置的是不久前加入的華裔科學(xué)家Dean Li博士。Perlmutter是K藥王朝的主要締造者,這也是制藥史上最成功的開發(fā)案例之一。但現(xiàn)在也有分析師質(zhì)疑默沙東過度依賴這個單一產(chǎn)品,產(chǎn)品線不夠多樣化。
Continue reading …


























 微信號:美中藥源
微信號:美中藥源